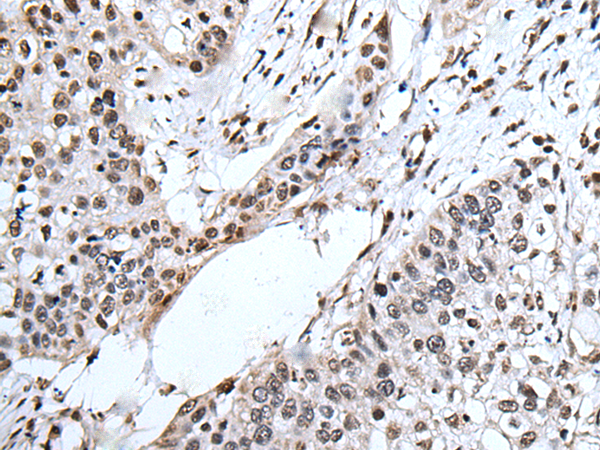
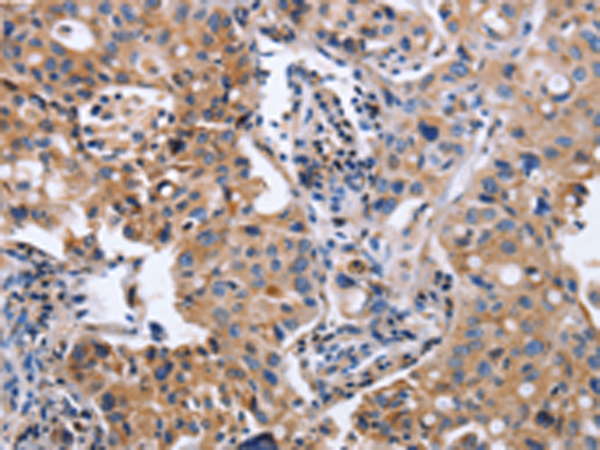
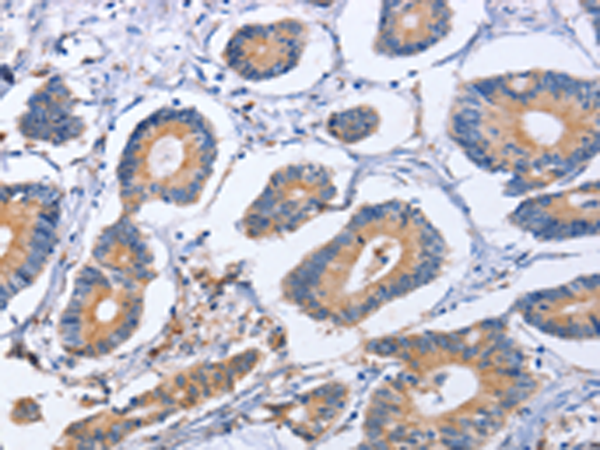
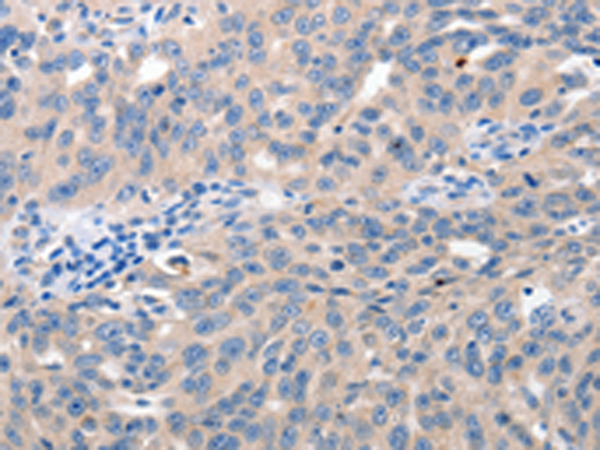

-
分类: 科研抗体货号: P07391别名: LPS; PIT; PPS; VWS; OFC6; PPS1; VWS1应用: WB,IHC反应种属: Human, Mouse
-
分类: 科研抗体货号: P07389别名: MUM1; LSIRF; SHEP8; NF-EM5应用: IHC反应种属: Human, Mouse
-
分类: 科研抗体货号: P07404别名: UKLF应用: IHC反应种属: Human
-
分类: 科研抗体货号: P07388别名:应用: IHC反应种属: Human, Mouse
-
分类: 科研抗体货号: P07419别名:应用: IHC反应种属: Human, Mouse
-
分类: 科研抗体货号: P07403别名: HK2, HCK1, PCN1, ATFB7, HPCN1, KV1.5应用: WB反应种属: Human, Mouse, Rat
-
分类: 科研抗体货号: P07385别名: GT; CD61; GP3A; BDPLT2; GPIIIa; BDPLT16应用: WB,IHC反应种属: Human, Mouse, Rat
-
分类: 科研抗体货号: P07417别名: LEF-1; TCF10; TCF7L3; TCF1ALPHA应用: IHC反应种属: Human, Mouse, Rat
-
分类: 科研抗体货号: P07402别名: JNK; JNK1; PRKM8; SAPK1; JNK-46; JNK1A2; SAPK1c; JNK21B1/2应用: WB,IHC反应种属: Human, Mouse, Rat
-
分类: 科研抗体货号: P07384别名: EDF; FRP应用: WB,IHC反应种属: Human, Mouse, Rat

鄂公网安备42018502007531号
鄂公网安备42018502007531号

